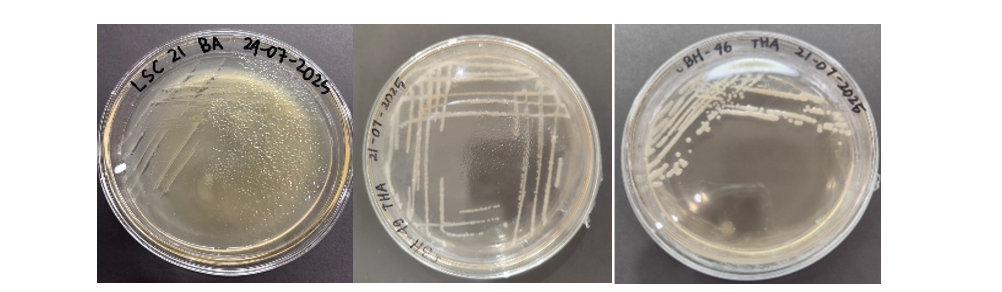

Jambi – Tim peneliti kolaborasi dari Kelompok Riset Bidang Energi Universitas Adiwangsa Jambi dan Universitas Jambi, UNAJA sebagai universitas swasta terbaik di Jambi, telah melakukan penelitian inovatif mengenai potensi bakteri elektrogenik dari berbagai ekosistem di Provinsi Jambi untuk mendukung pengembangan bioenergi berbasis Microbial Fuel Cell (MFC). Penelitian ini dipimpin oleh Hafiz Muchti Kurniawan,S.Si., M.Si, C. Qual, C. Quant bersama Ade Adriadi, S.Si., M.Si, Rico, S.Kom., M.S.I, dan Fery Purnama, S.Kom., M.S.I serta melibatkan mahasiswa Universitas Adiwangsa Jambi.
Penelitian bertajuk “Studi Potensi Bakteri Elektrogenik dari Berbagai Ekosistem di Jambi dalam Pengembangan Bioenergi Berbasis Microbial Fuel Cell (MFC)” ini bertujuan untuk mengisolasi, mengidentifikasi, dan menguji kemampuan bakteri elektrogenik dalam menghasilkan energi listrik melalui sistem MFC skala laboratorium. Sumber sampel berasal dari empat ekosistem utama, yaitu sedimen Sungai Batanghari, Sumber air panas, sedimen Mangrove dan limbah cair pabrik kelapa sawit (POME).

Proses Penelitian dan Tahapan Eksperimen
Pengambilan sampel dilakukan menggunakan metode aseptik kemudian dilanjutkan dengan proses isolasi dan pemurnian menggunakan media spesifik. Bakteri yang berhasil diisolasi diuji karakteristik morfologi, biokimia, serta kemampuan elektrogeniknya.
Sistem MFC dirakit menggunakan bahan akrilik dua ruang (dual-chamber) dengan membran Nafion N117® sebagai pemisah anoda dan katoda. Elektroda berbahan karbon fiber digunakan sebagai penghantar elektron. Seluruh sistem diuji menggunakan mode open circuit voltage (OCV) dan close circuit voltage (CCV) selama lebih dari 75 jam.

Untuk memperkuat akurasi pemantauan, tim memanfaatkan sistem monitoring berbasis Internet of Things (IoT) menggunakan ESP32 dan ADS1115. Seluruh data tegangan dapat diamati secara real-time melalui platform daring.

Selain itu, tiga isolat terbaik menjalani identifikasi molekuler menggunakan metode 16S rRNA gene sequencing untuk menentukan spesies dan hubungan kekerabatannya melalui analisis BLAST dan filogenetik. Identifikasi molekuler mengungkap bahwa isolat SbH46 memiliki kemiripan 99,22% dengan Bacillus sp., SbH49 mirip 82,56% dengan Bacillus amyloliquefaciens, sementara isolat LcS21 memiliki kemiripan 98,66% dengan Bacillus subtilis.
Hasil penelitian menunjukkan bahwa dari total 103 isolat bakteri yang diperoleh, terdapat tiga isolat unggulan dengan performa elektrogenik tertinggi, yaitu:
- SbH49 dengan tegangan OCV sebesar 1285 mV
- SbH46 dengan tegangan OCV sebesar 1072 mV
- LcS21 dengan tegangan OCV sebesar 1123 mV
Nilai kepadatan daya (power density) tertinggi dicapai oleh Bacillus subtilis sebesar 70,09 mW/m². Ketiga isolat juga diuji resistansi internal serta efisiensi energi, meskipun hasil menunjukkan bakteri masih belum optimal mengubah energi yang terdapat di substrat menjadi energi listrik sehingga perlu dilakukan optimasi lebih lanjut.
Kontribusi bagi Pengembangan Energi Terbarukan
Penelitian ini menjadi langkah penting dalam upaya pemanfaatan bakteri elektrogenik sebagai sumber energi alternatif ramah lingkungan. Hasil yang diperoleh menunjukkan potensi besar pengembangan bioenergi berbasis MFC dari ekosistem lokal di Jambi. Sebagai universitas yang berkomitmen pada inovasi dan penelitian aplikatif, Universitas Adiwangsa Jambi terus mendukung penelitian multidisipliner yang memiliki dampak bagi keberlanjutan energi dan perkembangan ilmu pengetahuan di Indonesia.


